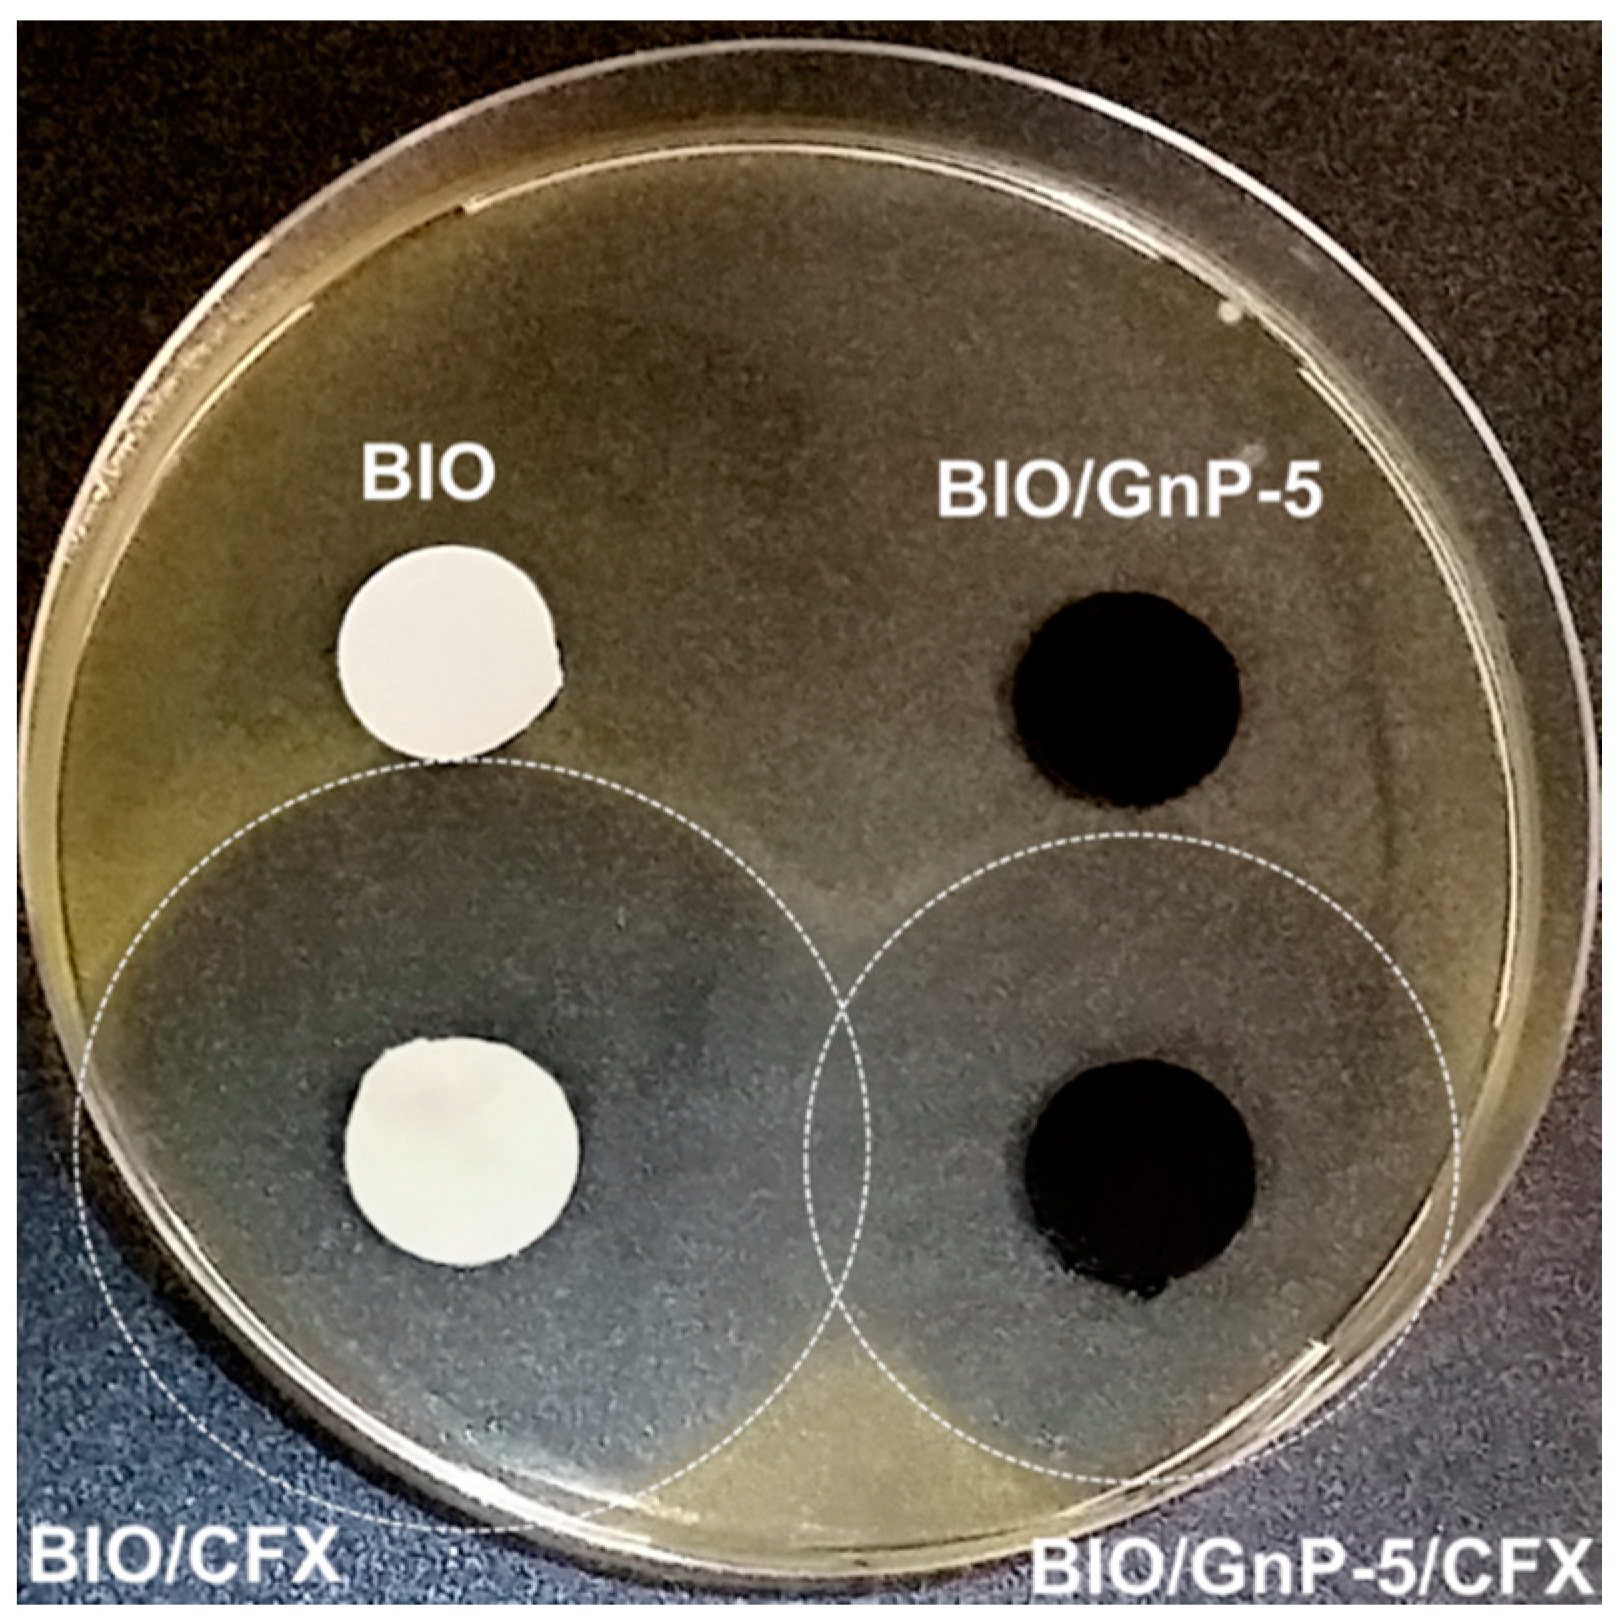

Effect of Graphene Nanoplatelets on the Physical and Antimicrobial Properties of Biopolymer-Based Nanocomposites
Abstract
:1. Introduction
2. Materials and Methods
2.1. Materials
2.2. Preparation of Nanocomposites and the Incorporation of CFX
2.3. Characterizations
3. Results and Discussion
3.1. Properties of Nanocomposites
3.2. Properties of Antimicrobial Nanocomposites
4. Conclusions
Acknowledgments
Author Contributions
Conflicts of Interest
References
- Van de Velde, K.; Kiekens, P. Biopolymers: Overview of several properties and consequences on their applications. Polym. Test. 2002, 21, 433–442. [Google Scholar] [CrossRef]
- Scaffaro, R.; Botta, L.; Sanfilippo, M.; Gallo, G.; Palazzolo, G.; Puglia, A.M. Combining in the melt physical and biological properties of poly(caprolactone) and chlorhexidine to obtain antimicrobial surgical monofilaments. Appl. Microbiol. Biotechnol. 2013, 97, 99–109. [Google Scholar] [CrossRef] [PubMed]
- Scaffaro, R.; Botta, L.; Gallo, G.; Puglia, A.M. Influence of Drawing on the Antimicrobial and Physical Properties of Chlorhexidine-Compounded Poly(caprolactone) Monofilaments. Macromol. Mater. Eng. 2015, 300, 1268–1277. [Google Scholar] [CrossRef]
- Scaffaro, R.; Lopresti, F.; Botta, L.; Rigogliuso, S.; Ghersi, G. Preparation of three-layered porous PLA/PEG scaffold: Relationship between morphology, mechanical behavior and cell permeability. J. Mech. Behav. Biomed. Mater. 2016, 54, 8–20. [Google Scholar] [CrossRef] [PubMed]
- La Mantia, F.P.; Botta, L.; Morreale, M.; Scaffaro, R. Effect of small amounts of poly(lactic acid) on the recycling of poly(ethylene terephthalate) bottles. Polym. Degrad. Stab. 2012, 97, 21–24. [Google Scholar] [CrossRef]
- Scarfato, P.; Di Maio, L.; Incarnato, L. Recent advances and migration issues in biodegradable polymers from renewable sources for food packaging. J. Appl. Polym. Sci. 2015, 48. [Google Scholar] [CrossRef]
- Fiore, V.; Botta, L.; Scaffaro, R.; Valenza, A.; Pirrotta, A. PLA based biocomposites reinforced with Arundo donax fillers. Compos. Sci. Technol. 2014, 105, 110–117. [Google Scholar] [CrossRef]
- Botta, L.; Fiore, V.; Scalici, T.; Valenza, A.; Scaffaro, R. New Polylactic Acid Composites Reinforced with Artichoke Fibers. Materials 2015, 8, 7770–7779. [Google Scholar] [CrossRef]
- Botta, L.; Mistretta, M.C.; Palermo, S.; Fragalà, M.; Pappalardo, F. Characterization and Processability of Blends of Polylactide Acid with a New Biodegradable Medium-Chain-Length Polyhydroxyalkanoate. J. Polym. Environ. 2015, 23, 478–486. [Google Scholar] [CrossRef]
- Scaffaro, R.; Morreale, M.; Mirabella, F.; La Mantia, F.P. Preparation and Recycling of Plasticized PLA. Macromol. Mater. Eng. 2011, 296, 141–150. [Google Scholar] [CrossRef]
- Scarfato, P.; Avallone, E.; Galdi, M.R.; Maio, L.; Incarnato, L. Preparation, characterization, and oxygen scavenging capacity of biodegradable α-tocopherol/PLA microparticles for active food packaging applications. Polym. Compos. 2015. [Google Scholar] [CrossRef]
- Bordes, P.; Pollet, E.; Avérous, L. Nano-biocomposites: Biodegradable polyester/nanoclay systems. Prog. Polym. Sci. 2009, 34, 125–155. [Google Scholar] [CrossRef]
- Raquez, J.-M.; Habibi, Y.; Murariu, M.; Dubois, P. Polylactide (PLA)-based nanocomposites. Prog. Polym. Sci. 2013, 38, 1504–1542. [Google Scholar] [CrossRef]
- Scaffaro, R.; Botta, L.; Passaglia, E.; Oberhauser, W.; Frediani, M.; Di Landro, L. Comparison of different processing methods to prepare poly(lactid acid)-hydrotalcite composites. Polym. Eng. Sci. 2014, 54, 1804–1810. [Google Scholar] [CrossRef]
- La Mantia, F.P.; Mistretta, M.C.; Scaffaro, R.; Botta, L.; Ceraulo, M. Processing and characterization of highly oriented fibres of biodegradable nanocomposites. Compos. Part B Eng. 2015, 78, 1–7. [Google Scholar] [CrossRef]
- Di Maio, L.; Scarfato, P.; Milana, M.R.; Feliciani, R.; Denaro, M.; Padula, G.; Incarnato, L. Bionanocomposite polylactic acid/organoclay films: Functional properties and measurement of total and lactic acid specific migration. Packag. Technol. Sci. 2014, 27, 535–547. [Google Scholar] [CrossRef]
- Paul, D.R.; Robeson, L.M. Polymer nanotechnology: Nanocomposites. Polymer 2008, 49, 3187–3204. [Google Scholar] [CrossRef]
- Martínez-Sanz, M.; Bilbao-Sainz, C.; Du, W.X.; Chiou, B.S.; Williams, T.G.; Wood, D.F.; Imam, S.H.; Orts, W.J.; Lopez-Rubio, A.; Lagaron, J.M. Antimicrobial Poly(lactic acid)-Based Nanofibres Developed by Solution Blow Spinning. J. Nanosci. Nanotechnol. 2015, 15, 616–627. [Google Scholar] [CrossRef] [PubMed]
- Tawakkal, I.S.M.A.; Cran, M.J.; Miltz, J.; Bigger, S.W. A review of poly(lactic acid)-based materials for antimicrobial packaging. J. Food Sci. 2014, 79, R1477–R1490. [Google Scholar] [CrossRef] [PubMed]
- Xu, X.; Yang, Q.; Wang, Y.; Yu, H.; Chen, X.; Jing, X. Biodegradable electrospun poly(l-lactide) fibers containing antibacterial silver nanoparticles. Eur. Polym. J. 2006, 42, 2081–2087. [Google Scholar] [CrossRef]
- Jin, T.; Zhang, H. Biodegradable polylactic acid polymer with nisin for use in antimicrobial food packaging. J. Food Sci. 2008, 73, M127–M134. [Google Scholar] [CrossRef] [PubMed]
- Liu, L.S.; Finkenstadt, V.L.; Liu, C.K.; Jin, T.; Fishman, M.L.; Hicks, K.B. Preparation of poly(lactic acid) and pectin composite films intended for applications in antimicrobial packaging. J. Appl. Polym. Sci. 2007, 106, 801–810. [Google Scholar] [CrossRef]
- Toncheva, A.; Paneva, D.; Manolova, N.; Rashkov, I. Electrospun poly(l-lactide) membranes containing a single drug or multiple drug system for antimicrobial wound dressings. Macromol. Res. 2011, 19, 1310–1319. [Google Scholar] [CrossRef]
- Douglas, P.; Andrews, G.; Jones, D.; Walker, G. Analysis of in vitro drug dissolution from PCL melt extrusion. Chem. Eng. J. 2010, 164, 359–370. [Google Scholar] [CrossRef]
- Nostro, A.; Scaffaro, R.; Ginestra, G.; D’Arrigo, M.; Botta, L.; Marino, A.; Bisignano, G. Control of biofilm formation by poly-ethylene-co-vinyl acetate films incorporating nisin. Appl. Microbiol. Biotechnol. 2010, 87, 729–737. [Google Scholar] [CrossRef] [PubMed]
- Nostro, A.; Scaffaro, R.; D’Arrigo, M.; Botta, L.; Filocamo, A.; Marino, A.; Bisignano, G. Study on carvacrol and cinnamaldehyde polymeric films: Mechanical properties, release kinetics and antibacterial and antibiofilm activities. Appl. Microbiol. Biotechnol. 2012, 96, 1029–1038. [Google Scholar] [CrossRef] [PubMed]
- Nostro, A.; Scaffaro, R.; D’Arrigo, M.; Botta, L.; Filocamo, A.; Marino, A.; Bisignano, G. Development and characterization of essential oil component-based polymer films: A potential approach to reduce bacterial biofilm. Appl. Microbiol. Biotechnol. 2013, 97, 9515–9523. [Google Scholar] [CrossRef] [PubMed]
- Nostro, A.; Scaffaro, R.; Botta, L.; Filocamo, A.; Marino, A.; Bisignano, G. Effect of temperature on the release of carvacrol and cinnamaldehyde incorporated into polymeric systems to control growth and biofilms of Escherichia coli and Staphylococcus aureus. Biofouling 2015, 31, 639–649. [Google Scholar] [CrossRef] [PubMed]
- Perale, G.; Casalini, T.; Barri, V.; Müller, M.; Maccagnan, S.; Masi, M. Lidocaine release from polycaprolactone threads. J. Appl. Polym. Sci. 2010, 117, 3610–3614. [Google Scholar] [CrossRef]
- Scaffaro, R.; Botta, L.; Marineo, S.; Puglia, A.M. Incorporation of nisin in poly (ethylene-co-vinyl acetate) films by melt processing: A study on the antimicrobial properties. J. Food Prot. 2011, 74, 1137–1143. [Google Scholar] [CrossRef] [PubMed]
- Scaffaro, R.; Botta, L.; Gallo, G. Photo-oxidative degradation of poly(ethylene-co-vinyl acetate)/nisin antimicrobial films. Polym. Degrad. Stab. 2012, 97, 653–660. [Google Scholar] [CrossRef]
- Campos-Requena, V.H.; Rivas, B.L.; Pérez, M.A.; Garrido-Miranda, K.A.; Pereira, E.D. Polymer/clay nanocomposite films as active packaging material: Modeling of antimicrobial release. Eur. Polym. J. 2015, 71, 461–475. [Google Scholar] [CrossRef]
- Caço, A.I.; Varanda, F.; Pratas de Melo, M.J.; Dias, A.M.A.; Dohrn, R.; Marrucho, I.M. Solubility of Antibiotics in Different Solvents. Part II. Non-Hydrochloride Forms of Tetracycline and Ciprofloxacin. Ind. Eng. Chem. Res. 2008, 47, 8083–8089. [Google Scholar] [CrossRef]
- Botta, L.; Scaffaro, R.; La Mantia, F.P.; Dintcheva, N.T. Effect of different matrices and nanofillers on the rheological behavior of polymer-clay nanocomposites. J. Polym. Sci. Part B Polym. Phys. 2010, 48, 344–355. [Google Scholar] [CrossRef]
- Di Maio, L.; Garofalo, E.; Scarfato, P.; Incarnato, L. Effect of polymer/organoclay composition on morphology and rheological properties of polylactide nanocomposites. Polym. Compos. 2015, 36, 1135–1144. [Google Scholar] [CrossRef]
- Narimissa, E.; Gupta, R.K.; Kao, N.; Choi, H.J.; Jollands, M.; Bhattacharya, S.N. Melt rheological investigation of polylactide-nanographite platelets biopolymer composites. Polym. Eng. Sci. 2014, 54, 175–188. [Google Scholar] [CrossRef]
- Li, Y.; Zhu, J.; Wei, S.; Ryu, J.; Sun, L.; Guo, Z. Poly (propylene)/graphene nanoplatelet nanocomposites: melt rheological behavior and thermal, electrical, and electronic properties. Macromol. Chem. Phys. 2011, 212, 1951–1959. [Google Scholar] [CrossRef]
- Saha, N.R.; Sarkar, G.; Roy, I.; Rana, D.; Bhattacharyya, A.; Adhikari, A.; Mukhopadhyay, A.; Chattopadhyay, D. Studies on methylcellulose/pectin/montmorillonite nanocomposite films and their application possibilities. Carbohydr. Polym. 2016, 136, 1218–1227. [Google Scholar] [CrossRef] [PubMed]
- Keawchaoon, L.; Yoksan, R. Preparation, characterization and in vitro release study of carvacrol-loaded chitosan nanoparticles. Coll. Surf. B Biointerfaces 2011, 84, 163–171. [Google Scholar] [CrossRef] [PubMed]

| Sample Code | Bio-Flex® F2110 (BIO) (w/w %) | Graphene Nanoplatelets (GnPs) (w/w %) | Ciprofloxacin (CFX) (w/w %) |
|---|---|---|---|
| BIO | 100 | – | – |
| BIO/GnP-1 | 99 | 1 | – |
| BIO/GnP-5 | 95 | 5 | – |
| BIO/CFX | 95 | – | 5 |
| BIO/GnP-5/CFX | 90 | 5 | 5 |
| Samples | E (MPa) | TS (MPa) | EB (%) |
|---|---|---|---|
| BIO | 140 ± 5.8 | 11.6 ± 0.5 | 165 ± 7.2 |
| BIO/GnP-1 | 168 ± 6.2 | 11.1 ± 0.4 | 151 ± 6.1 |
| BIO/GnP-5 | 195 ± 6.8 | 10.6 ± 0.6 | 135 ± 6.9 |
| Samples | E (MPa) | TS (MPa) | EB (%) |
|---|---|---|---|
| BIO/CFX | 150 ± 5.1 | 10.4 ± 0.5 | 130 ± 9.7 |
| BIO/GnP-5/CFX | 206 ± 7.1 | 10.2 ± 0.6 | 121 ± 9.9 |
© 2016 by the authors; licensee MDPI, Basel, Switzerland. This article is an open access article distributed under the terms and conditions of the Creative Commons Attribution (CC-BY) license (http://creativecommons.org/licenses/by/4.0/).
Share and Cite
Scaffaro, R.; Botta, L.; Maio, A.; Mistretta, M.C.; La Mantia, F.P. Effect of Graphene Nanoplatelets on the Physical and Antimicrobial Properties of Biopolymer-Based Nanocomposites. Materials 2016, 9, 351. https://doi.org/10.3390/ma9050351
Scaffaro R, Botta L, Maio A, Mistretta MC, La Mantia FP. Effect of Graphene Nanoplatelets on the Physical and Antimicrobial Properties of Biopolymer-Based Nanocomposites. Materials. 2016; 9(5):351. https://doi.org/10.3390/ma9050351
Chicago/Turabian StyleScaffaro, Roberto, Luigi Botta, Andrea Maio, Maria Chiara Mistretta, and Francesco Paolo La Mantia. 2016. "Effect of Graphene Nanoplatelets on the Physical and Antimicrobial Properties of Biopolymer-Based Nanocomposites" Materials 9, no. 5: 351. https://doi.org/10.3390/ma9050351
APA StyleScaffaro, R., Botta, L., Maio, A., Mistretta, M. C., & La Mantia, F. P. (2016). Effect of Graphene Nanoplatelets on the Physical and Antimicrobial Properties of Biopolymer-Based Nanocomposites. Materials, 9(5), 351. https://doi.org/10.3390/ma9050351

